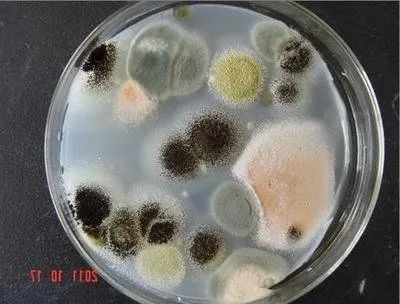

夏季炎炎与秋季的闷热
“神器”空调 不停的在工作
那么问题来了
你家的空调清洗了吗?
。




随着气温攀升
市民纷纷开启了空调模式
但许久未清洗的空调
很可能就成为
呼吸系统的“杀手



起初谢先生以为自己只是普李季霏通感冒,自行服用消炎、退热的药物后未见好转,仍反复发热,甚至出现了呼吸困难的情况,这才赶紧前往医院就诊。
就医后,医生发现患者高热且肺部有严重的炎症,白细胞却升高不明显。
“患者入院的时候是持续高烧烧到了40℃,浑身疼痛、头痛、没有食欲,整个身体软绵绵的。”随后经支气管肺泡灌洗液送检后确诊为“军团菌肺炎”.
纪爱妍
医生介绍
军团菌肺炎是一类常见非典型性病原体导致的肺炎,通?;嵋鹬刂⒎窝?,它是一个叫军团菌的细菌引起的肺炎,与常见的细菌不一样。军团菌存在于自然环境中,其主要传染源是水源和空调系统,常经供水系统、空调和雾化进入人体,从而引起感染。感染后表现为白细胞升高不明显,全身症状明显。
“在家吹空调,空调也很久没有清洗过,就一直吹,吹的时候感觉还好,起来后就感觉不舒服?!毙幌壬?。
空调长时间不用
过滤网、散热片和出风滚轮
都会积聚大量灰尘和污垢
吹出来还有异味
仅难闻这么简单吗
别天真
它同时夹杂着数以亿计的细菌
甚至还有??!毒!
“这个患者就是开了空调,空调很久没有清洗,因为这个军团菌最常见的就是存在于空调系统里,所以像家里的空调,最少每年要清理一次?!?/p>
医生提醒
空调在长时间未使用情况下,一定要对空调系统进行常规检测和消毒;平时注意按时开窗通风,预防军团菌肺炎的发生。
觉得空调清洗难度系数太高?

注
“别急,看这里”
教你如何清洗家用空调
如何判断空调是否需要清洗?
如果过滤网上林志玲日本再发现积压灰尘过多,这时候空调应该马上进行清洁。最好是找专业清洗师傅清洗消毒,设备清洗药剂消毒药剂齐全,技术精湛,省时省力健康安全!
空调运行时,如果感觉室内有异味(类似发霉味),那么空调就需要清洗了。最好是找专业清洗师傅清洗消毒,设备清洗药剂消毒药剂齐全,技术精湛,省时省力健康安全!
这些看不见的污垢
很可能就是导致你生病的原因
建议家里的空调、洗衣机等家具
最好都定期清洗,自己在家清洗空调往往只是清洗了表面,需要对我们的空调高位杀菌,赶紧找专业的兵管家家电清洗来做一次健康大检方伟中查清洗消毒吧。

HAPPY DAY
3分钟前来自华为手机端
今天找兵管家的清洗师傅来清洗了空调和油烟机,太干净了,跟新买的一样,开心,好评!有需要的可以帮你联系,现在有优惠!



1小时前

邻居美美等369人点赞:推荐一下清洗公司啊,我家的也脏了





